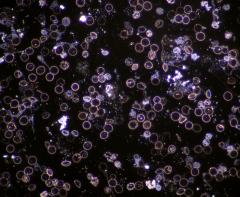
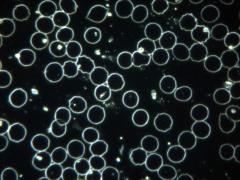
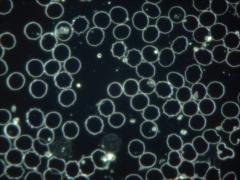

(--Lacerta hot product: LIS-CDF)
(0 JPY netto)
(Bruttopreise sind mit 19% bzw. 7% MWSt kalkuliert. Sollte die MWSt in Ihrem Land höher sein, übernimmt LACERTA GmbH die Differenz.)
zzgl. Versand
Einblick: binokular
Unterkategorie: Dunkelfeld
Max.Vergr.: 1000x
Versandgewicht: 13kg (Versandkosten)
Lieferbarkeit
(Der Lagerbestand dient nur zur Information und beinhaltet auch bereits reservierte Exemplare)
Wien: Wir bestellen gerne für Sie!
Linz: Wir bestellen gerne für Sie!
Lager: Wir bestellen gerne für Sie!
Öffnungszeiten
Woanders billiger? weiter...
| Wir empfehlen auch: | ||
|---|---|---|
|
LIS232set 109.90 EUR |

|
|
|
MicroqX... 469.90 EUR |

|
|
|
MicroqS... 439.90 EUR |

|
|
|
MicroqX... 859.90 EUR |

|
|
Kontrastreiches Dunkelfeld, ohne Wärmeentwicklung
Kernstück ist
die extrem starke LED-Beleuchtung, integriert in einen Cardioid
DarkField (CDF) Kondensor. Diese Einheit wird durch ein kurzes Kabel mit 12V gespeist.
Sie brauchen KEINEN zusätzlichen Lichkabel! Auch keine 150W Halogenbeleuchtung mit sperrigen Gehäuse, großer Abwärme und Lüftergeräuschen. Auch kein teurer Lampenwechsel mehr, die Beleuchtung des LIS-CDF ist wartungsfrei! Kein Zusatztisch in der Ordination um Vibrationen zu vermeiden, kein Kabelsalat, welcher bei der Untersuchung stört!
Die LACERTA CDF (Cardioid Dark Field) Mikroskope wurden bereits im
September 2014 auf der Fotokina Köln mit großem Erfolg präsentiert!
Konfiguration
Optik:
- 4x Plan-Achromat (N.A.=0,10)
- 10x Plan-Achromat (N.A.=0,25)
- 40x Plan-Achromat (N.A.=0,66)
- 100x Plan-Achromat mit Irisblende (N.A.=0.5-1.25)
- 10xWF20 Okularpaar mit langen Augenabstand (auch für Brillenträger geeignet)
- Ölimmersions CARDIOID Dunkelfeldkondensor (N.A.=1,36) mit integrierter LED-Beleuchtung
- Abbe Kondensor N.A.=1,25 für Hellfeld, vorbereitet für Phasenkontrastschieber
(als Alternative auch SWING-OUT-Kondensor wählbar, ohne Aufpreis) - Full-Köhler Beleuchtung (Kollektor mit Leuchtfeldblende)
Mikroskop:
- Trinokular Kopf (30 Grad geneigt, Augenabstand Verstellbereich 55-75mm)
- Großfeld Kameraanschlussmöglichkeit (back-focus = 92mm), wir bieten fertige Adaptersets an, auch für Vollformat-Kameras!
- Fünffacher Objektivrevolver, kugelgelagert für höchste Präzision
- Überdimensionierter Kreuztisch 175x145mm, mit XY Feinbewegungseinheit (Verstellbereich 75x50mm)
- Filterschublade (vorbereitet für Polarisations-Beobachtung)
- Scharfstellung durch Grob- und Feintrieb mit 0,002mm Genauigkeit
- 230V Stromversorgung für Hellfeld, 12V für Cardioid LED-Beleuchtungen
- Helligkeitsregelung durch Drehregler (sowohl bei Hellfeld, als auch bei Dunkelfeld)
Erweiterungen (optional)
- Kamera-Adapter aller Art (C-Mount, Stand-Alone HDMI, Spiegelreflex APS-C, Spiegelreflex Vollformat)
- Phasenkontrast Untersuchung (10x, 20x, 40x, 100x)
- Polarisationsuntersuchung (sowohl qualitative als auch quantitative Polarisation)
- Dunkelfelduntersuchung ganz ohne Ölimmersion (bis 400x Vergr.)
- Infinity Plan Objektive mit 2,5x (N.A.=0,07), 20x (N.A.=0,40), oder 60x (N.A.=0,8)
Serviceleistungen, Support (optional)
- Technikbasierte Mikroskopkurse in Wien (Kleingruppen, bis 4 Personen)
- Vor Ort Service und/oder Schulung innerhalb Österreich
- Einzelanfertigung um Ihre bestehende Kamera an das LIS-CDF anzupassen
Kaufentscheidungshilfe:
- Wir gewähren 6 Jahre Garantie auf alle LACERTA LIS Mikroskope! (ausser Leuchtkörper)
Lieferzeit:
die aktuelle Lieferzeiten alle unsere Flagschiffprodukte entnehmen Sie von der Startseite (bitte ganz runter scrollen) oder KLICKEN SIE HIER.
Unser Spezialservice für Sie:
- Vorführung und Einschulung in Wien oder Linz nach Terminvereinbarung möglich
- Wir stellen sogar unser eigenes Blut zur Verfügung, damit Sie das Instrument testen können!
- Sie können das Dunkelfeldmikroskop sowohl visuell als auch fotografisch (Live Camera, DSLR, Beamer, TV, usw...) verwenden. Wir helfen Ihnen gerne die richtigen Adaptionen für Ihr bereits BESTEHENDES Equipment zusammenzustellen.
#Dunkelfeldmikroskopie #szn
 |
LIS232set | Parfokales Adapterset für LIS (Lacerta Infinity System) zur Mikroskopkamera mit 23.2mm Steckmaß. Das Set besteht aus: LisMicHel, MicHel, T2n232, T2T28, T2T2varS (zB für MicroQ) | 109.90 EUR | |
 |
MicroqXLITEscr | Stand Alone Kamera mit 9 Zoll LCD Display, für Astronomie und Mikroskopie - On-board Operation System, Fotos/Videos können auf SD-Karte gespeichert werden | 469.90 EUR | |
 |
MicroqSP-120 | 12MP MicroQ-SP MikroCam (SP=speed, Schnelle Mikroskopkamera mit SONY IMX577 Sensor: 4056 x 3040) | 439.90 EUR | |
 |
MicroqXFB178 | IMX178c Stand Alone WiFi autofokus HDMI Kamera mit 6.3MPixel SONY EXMOR Sensor (3096x2080). On-board Operations System, mit Maus steuerbar. Fotos und Videos können direkt an SD-Karte gespeichert werden | 859.90 EUR | |
 |
MicroqXLITE307 | XLITE307c HDMI MikroCam (Stand Alone Mikroskopkamera mit SONY IMX307 back illuminated Sensor). On-board Operations System, mit Maus steuerbar. Fotos und Videos können direkt an SD-Karte gespeichert werden | 329.90 EUR | |
 |
CleanSetLa | LACERTA Reinigungsset für Optiken: Reinigungsflüssigkeit, Mikrofasertuch, Blasebalg, Reinigungspinsel | 19.90 EUR | |
 |
Slides50EU | 50 Stk Objektträger mit Mattrand, hohe Qualität, hergestellt in der EU | 9.90 EUR | |
 |
CoverD200LA | 200 Stk 24x24mm Deckplättchen, besonders hohe Qualität | ONLY SUPPORT | |
 |
BagMik250 | 250mm breite gepolsterte Mikroskop-Transporttasche bis 400mm Höhe (für Primostar, Lacerta LIS, BIM312, STM45) mit innerem Fach für Zubehör | 61.90 EUR |
LIS-CDF_EAN-13_9120069912128.gif
LIS-CDF_LIS-CDF_Anleitung_1.pdf
LIS-CDF_PRINT.png
WELCHES TELESKOP SOLL ICH KAUFEN?
Fragen Sie uns - Kontakt
Unser Shop in WIEN
Unser Shop in LINZ
Adresse und Öffnungszeiten
Zahlung und Versand
Vor dem Kauf (Ratgeber)
Rücksendungs-Formular
astronomieforum.at
astronomie.de
mikroskopie-forum.at
bird.at Forum
Links und Partners
Veranstaltungen (Kalendarium)
Firmendaten
Allgemeine Geschäftsbedingungen (AGB)
Haftungsausschluss
Urheberrecht (Copyright)
Widerrufsbelehrung
© 2005-2026 Lacerta GmbH.
All rights reserved.

 Zahlung und Versand
Zahlung und Versand